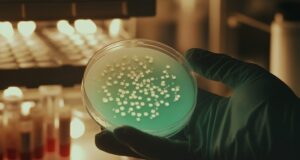

- Publicidad -














publicidadpastoconstruoutlet
Neora
Unknown
Capturadepantalla2021-04-05alas192628
Capturadepantalla2022-09-12alas044556
Capturadepantalla2023-02-11alas195813
Síguenos en Instagram @vanguardiasonora
© Derechos reservados Vanguardia 2020.